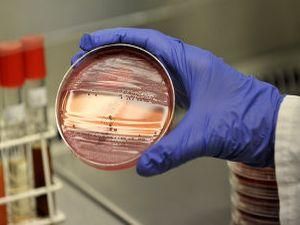
Германии определиться с инфекцией помогает Китай Германии определиться с инфекцией помогает Китай

"Корреспонденту "Известий" в кулуарах заседания немецких федеральных и земельных министров удалось узнать, что немцы уже обратились к ведущим зарубежным специалистам за помощью, но стараются не афишировать эти контакты. Причина: не хотят расписываться перед бундесбюргерами в своей беспомощности. Основной консультант - Пекинский институт геномики, который является крупнейшим в мире центром по изучению ДНК", - пишет издание.
Германии определиться с инфекцией помогает Китай
Пекинский институт геномики выступает консультантом Германии в вопросе решения проблем распространения кишечной инфекции.
